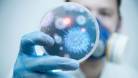

В мире появилась новая инфекция с кодовым названием "инфекция Х", об этом на брифинге в СЦК сообщил главный государственный санитарный врач Казахстана Жандарбек Бекшин, передаёт корреспондент Bnews.kz.
"По данным ВОЗ, ежегодно в мире регистрируется более миллиарда случаев инфекционных заболеваний. 16 миллионов заканчивается летальными исходами. Только за последние 20 лет появилось более 30 новых и возвращающихся инфекций. Это прежде всего денге, Эбола, короновирусная инфекция. И можно говорить о том, что в текущем году появилась новая инфекция, которая в ВОЗ зарегистрирована под кодовым названием "инфекция X". Она имеет на сегодня глобальный и угрожающий характер. Это новая угроза, которая возникла в этом году", - отметил он на пресс-конференции в Астане.
По его словам, специалисты ещё не смогли изучить новый вирус. Вместе с тем, он напомнил о том, что в мире все ещё сохраняется опасность развития вируса Эбола.
"Мы знаем, о том, что в 2014-2015 года в западно-африканских странах бушевал вирус Эбола. Заболело более 30 тысяч и более 10 тысяч случаев были летальными. Продолжается и в этом году. В Конго около 50 случаев было зарегистрировано. В этих условиях мы обращаем внимание и на другие случаи. Мы сегодня знаем, что в Казахстане имеются природные очаги чумы, Конго-крымской геморрагической лихорадки. У нас регистрируется заболеваемость бруцеллёзом. в этих условиях строительство и деятельность этой лаборатории актуальна для Казахстана", - добавил спикер.